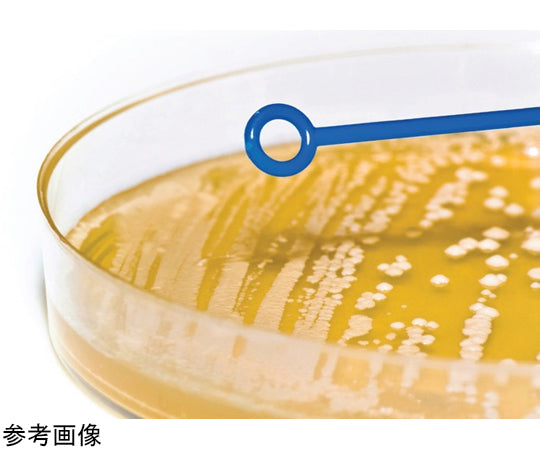

1
/
の
3
HEATHROW
Inoculating Needle/Loops 1uL Rigid Sterile pk1000 Blue 1箱(1000個入) HS81121B 1箱(1000個入)
Inoculating Needle/Loops 1uL Rigid Sterile pk1000 Blue 1箱(1000個入) HS81121B 1箱(1000個入)
通常価格
¥17,710
通常価格
セール価格
¥17,710
単価
/
あたり
(税込み)
受取状況を読み込めませんでした
Transfer bacterial cultures without risk of contamination.
The Inoculating Needle/Loops combination provides the choice to spread or pick colonies and cultures.
Combination provides choice to spread or pick colonies and cultures
Transfer bacterial cultures without risk of contamination
Use loop end to uniformly streak a gel surface
Use needle end for removal of colonies
Lot-to-lot traceability
組み合わせにより、コロニーと文化を広げるか選択するかの選択肢が得られます。
汚染のリスクなく細菌培養物を移送できます。
ループエンドを使ってゲル表面を均一に塗ります。
コロニーの除去には針先を使用します。
ロット間のトレーサビリティMaterial:Acrylonitrile Butadiene Styrene(ABS)
Color:Blue
Material:Rigid ABS
Loop(μL):1
L×D(in):7.9×0.2
L×D(cm):20×0.4
Sterile:Yes
Packaging(1000 per Box):50×20pk
色:ブルー
材質:硬質ABS
ループ(μL):1
長さ×奥行(インチ):7.9×0.2
長さ×奥行(cm):20×0.4
滅菌:有
包装:1000本/パック(50本×200パック)
メーカーウェブサイト
詳細を表示する